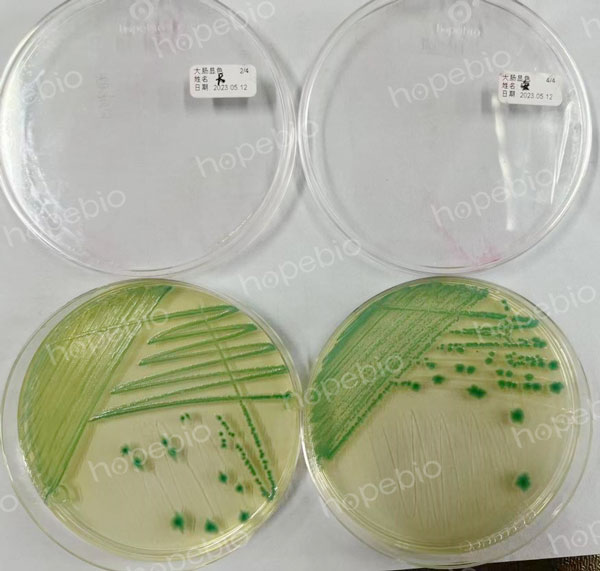

海博微信公众号
海博微信公众号
 海博天猫旗舰店
海博天猫旗舰店


 海博微信公众号
海博微信公众号
 海博天猫旗舰店
海博天猫旗舰店




志贺氏菌属(Shigella Castellani)是一类革兰氏阴性短小杆菌,是人类细菌性痢疾最为常见的病原菌,主要流行于发展中国家,通称痢疾杆菌,耐寒,能在普通琼脂培养基上经过24小时生长,形成直径达2mm大小、半透明的光滑型菌落。无芽胞,无荚膜,无鞭毛,多数有菌毛。是人和灵长类动物的肠道致病菌,引起细菌性痢疾。
志贺氏菌耐寒,在冰块中能生存3个月。在志贺氏菌中宋内志贺氏菌和福氏志贺氏菌在体外的生存力相对较强,志贺氏菌食物中毒主要由这两种志贺氏菌引起。
根据志贺氏菌抗原构造的不同,可分为四群48个血清型(包括亚型)。
(1)A群:又称痢疾志贺氏菌(Sh.dysenteriae),通称志贺氏痢疾杆菌。不发酵甘露醇。有12个血清型,其中8型又分为三个亚型。
(2)B群:又称福氏志贺氏菌(Sh.flexneri),通称福氏痢疾杆菌。发酵甘露醇。有15个血清型(含亚型及变种),抗原构造复杂,有群抗原和型抗原。根据型抗原的不同,分为6型,又根据群抗原的不同将型分为亚型;X、Y变种没有特异性抗原,仅有不同的群抗原。
(3)C群:又称鲍氏志贺氏菌(Sh.boydii),通称鲍氏痢疾杆菌。发酵甘露醇,有18个血清型,各型间无交叉反应。
(4)D群:又称宋内氏志贺氏菌(Sh.sonnei),通称宋内氏痢疾杆菌。发酵甘露醇,并迟缓发酵乳糖,一般需要3~4天。只有一个血清型。有两个变异相,即Ⅰ相和Ⅱ相;Ⅰ相为S型,Ⅱ相为R型。
在《GB 4789.5-2012食品安全国家标准 食品微生物学检验 志贺氏菌检验》中,列出了不同群属的主要生化特性。
表1 志贺氏菌属四个群的生化特征
用我司生产的生化鉴定条,可以清楚地看出其生化反应现象。

图1 宋内志贺氏菌CMCC(B)51592在生化鉴定条上的反应

图2 福氏志贺氏菌CMCC(B)51572在生化鉴定条中的反应
除以上生化特性外,宋内志贺氏菌还具有β-葡萄糖醛酸酶,该酶常常被用来作为大肠埃希氏菌的快速检测。这意味着在部分显色平皿和MUG液体试剂中,宋内志贺氏菌可以显示出和大肠埃希氏菌类似的颜色和荧光。
图3 大肠埃希氏菌ATCC25922(左)和宋内志贺氏菌CMCC(B)51592(右)在大肠杆菌显色平皿上显示出类似的颜色
相关标准:
注:本文属海博生物原创,未经允许不得转载。
上一篇:弧菌的活化及保存
| 相关文章: | ||



